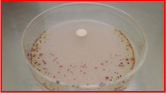
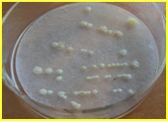
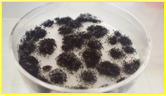
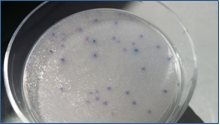
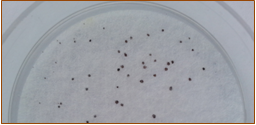

placas preparadas zonas tropicales: DryPlates para climas calientes que destrozan las placas preparadas convencionales
¡Placas preparadas de medio deshidratado estéril!
Las DryPlates® son placas preparadas, estériles y listas para su uso inmediato,
que ofrecen la ventaja de tener 1-2 años de caducidad, al estar elaboradas con medio deshidratado, que se hidrata con 1 ml de agua estéril en el momento de inocularlas (Activación).
Han sido diseñadas para que puedan soportar temperaturas extremas durante su transporte y almacenamiento.
El reparto inmediato y homogéneo del agua que las activa, se consigue gracias al Disco Nutriente, un disco fibroso de malla muy fina que contiene el medio de cultivo en polvo estéril junto con un desarrollo de MICROKIT, el hidragar, que permite la rehidratación en frío.
Enhorabuena por haber adquirido el sustituto del Siglo XXI de los medios deshidratados y de los medios preparados hidratados en placa o en frasco!
MODO DE EMPLEO
- Con unas pinzas, sacar un disco nutriente de su bolsa y colocar en la tapa de una placa DryPlates® recién abierta.
- Añadir a la base de la placa 1 ml de agua estéril (puede adquirirnos viales de 1 ml, frascos pinchables de 100 ml…) que quede bien centrada, ya que es mejor que el agua no toque las paredes internas de la placa, para que la hidratación sea mucho más rápida y homogénea, sin islas secas marginales en forma de media luna.
- Voltear la tapa con disco nutriente para volver a cerrar la placa, con cuidado para que el disco nutriente caiga centrado sobre la muestra; de este modo se repartirá homogéneamente en un instante. Si de todas formas, queda una media luna o una isla seca sin hidratar, inclinar la placa unos segundos, rotándola hasta que el agua embeba todo el disco nutriente.
Si se prefiere, puede tomar el disco nutriente con unas pinzas y colocarlo directamente sobre el ml de agua, previamente dispensado en el centro de la placa):
No añada el agua sobre el disco nutriente, ya que no difundirá homogéneamente. La formación de “islas secas” sin muestra, sólo debe preocupar si éstas son muy grandes, ya que al incubar desaparecerán.
INCUBACIÓN
- Sembrar la muestra en estría. IMPORTANTE: incubar en estufa con atmósfera húmeda (dejar 4 vasos llenos de agua en la estufa, uno en cada esquina), sin voltear las placas (el disco abajo) para que no se fugue parte de muestra durante la incubación. Nunca incube las DryPlates® directamente sobre la bandeja de la estufa, intercale dos placas vacías (como “podio base porta-placas” para poner entre la torre de placas y la base metálica de la estufa) para que la DryPlate® no se seque durante la incubación por el exceso de calor del metal: tenga en cuenta que hay menos de 1 mm de espesor de medio. Igualmente no deje que la torre de placas toque la paredes de la estufa. Las condiciones de incubación (tiempo y temperatura) son las estándar de cada medio: bacterias 35-37ºC, 1-3 días, hongos 21-25ºC, 3-5 días.
- Antes de leer, es muy importante verificar que la superficie de la placa sigue húmeda. Leer los resultados buscando sólo las estrías o colonias diana, que crecen del color indicado para cada medio en la etiqueta de su caja.
- Para uso en muestras de 1 mL de agua, añadir 1 ml de la muestra de agua en la DryPlates® deseada. En los demás parámetros del agua, y/o para mayores volúmenes, prehidratarlas poniendo 1 ml de agua estéril en la placa, añadir el disco nutriente y, una vez empapado, poner encima de éste la membrana filtrada por los 100-1000 ml de muestra.
- Para superficies, estriar un hisopo con el que haya barrido una muestra de superficies, sobre la DryPlates®, previamente hidratada con 1 ml de agua estéril. Para aires dejar la DryPlates® de cualquier medio, previamente hidratada con 1 ml de agua estéril, abierta durante 10-15 minutos en los puntos críticos de la sala, para realizar una estimación “de campo” de la flora ambiental (aunque es mejor usar un muestreador de impacto -consultar MBS- para obtener recuentos por m3 de aire)
CONSERVACIÓN Y PRECAUCIONES DE USO
Almacenar a temperatura ambiente (ideal 15-25ºC) ¡no en nevera!, ya que en ésta la humedad es más fácil que prehidrate y estropee los discos nutrientes. Eso sí, es imprescindible almacenar en lugar muy seco y oscuro, ya que la humedad y la luz dañan irreversiblemente los medios de cultivo deshidratados. Si trabaja en zonas de alta humedad atmosférica, almacene las DryPlates®, bien cerradas en su bolsa, dentro de una caja hermética “tupper” con silicagel o sacos antihumedad (ej: MICROKIT VRB747).
GAMA
-DryPlates®-MHS (Mueller Hinton cromogénico): DPP026- (caja 180u), colonias rojas para mejor visión de los halos de inhibición sobre el medio, color blanco. Mucho más rápidas que el Mueller Hinton clásico, lo cual puede salvar muchas vidas gracias al diagnóstico precoz de los antibióticos adecuados contra la cepa problema. Cajas de 180 u.
-DryPlates®-UTI: DPP027- (caja 180u), E.coli rosa-ocre, Proteus, Klebsiella y Enterococos verde-azulado, St.aureus crema-doradas
-DryPlates®-MacConkey: DPP022- (caja 180u), colonias rojas sobre medio púrpura
-DryPlates®-EC: DPP006- (caja 60u), bacterias coliformes rojas y E.coli azules sobre medio blanco
-DryPlates®-Pseudomonas aeruginosa: DPP014- (caja 60u), colonias rojas y fluorescentes sobre medio blanco. La más vendida en hospitales de Iberoamérica
-DryPlates®-X-Staphylococcus aureus: DPP009- (caja 60u), bacterias diana azul oscuro o púrpura, otros Staph. Turquesa, sobre medio blanco
-DryPlates®-Salmonella: DPP012- (caja 60u), -DryPlates®-XLD: DPP030- (caja 60u)
-DryPlates®-TSA cromogénico: DPP020- (caja 60 u) y DPP020+ (caja 1200 u): Bacterias generales. Colonias rojas que contrastan con el medio (color crema: TSA Pharmacopea, ISO 21149) cromogénico para mejor visión.
-DryPlates® -Sabouraud: DPP021- (caja 60 u) y DPP021+ (caja 1200 u): Recuento de hongos (mohos: colonias algodonosas; levaduras: colonias no algodonosas) en cosméticos y medicamentos, medio color crema Sabouraud Dextrosa Caf. Agar (Pharmacopea, ISO 16212), colonias de sus colores naturales (Arriba: Levadura Candida albicans; Abajo: Moho Aspergillus niger).
-DryPlates®-Vibrio: DPP010- (caja 60u), bacterias diana verde-azuladas
(V. parahaemolyticus) o rojas (V.cholerae) sobre medio blanco. La más vendida en Africa.
-DryPlates®-Candida: DPP016- (caja 60u), bacterias diana pardas sobre medio blanco
-DryPlates®-Listeria: DPP013- (caja 60u), bacterias diana verde-azuladas sobre medio blanco
-DryPlates®-Enterococos fecales: DPP017- (caja 60u), bacterias diana marrones sobre medio blanco
Otros muchos medios en DryPlates® para microbiología de alimentos, aguas, medicamentos, cosméticos…
placas preparadas zonas tropicales
NOTAS
El usuario final es el único responsable de la eliminación de los microorganismos según la legislación medioambiental vigente. Autoclavar antes de desechar a la basura. Diseño y fabricación 100% españoles. Derechos de explotación de la PATENTE concedidos en exclusiva a Laboratorios MICROKIT, S.L. tras 23 años de ensayos y mejoras para poder ofrecerle el mejor y más versátil producto de estas características. Validado en base a la Norma UNE-EN-ISO 16140, con recuperaciones equivalentes (>90%) a los mismos medios clásicos agarizados.
Si desea más información sobre nuestros DryPlates®-Microbiología clínica rellene nuestro formulario de contacto http://www.medioscultivo.com/contacto . O si lo prefiere póngase en contacto con nosotros a través de nuestro correo electrónico microkit@microkit.es o por teléfono en el nº 91-897 46 16
Haga sus consultas de este medio en: microkit@microkit.es
Haga sus pedidos de este medio en: pedidos@microkit.es
En este vídeo puedes entender mejor la hazaña de las DryPlates® y cómo usarlas:

ya se emplean de rutina miles de unidades en todo el mundo.
anual es necesaria en cualquier caso y más frecuentemente cuantos más muestreos se realicen. Las fábricas con varias plantas pueden tener un MBS por planta y un solo KIT de validación para todas ellas. También deben exigir que el importador tenga un KIT de calibración para poder externalizar las calibraciones y no tener que comprar el KIT de calibración.






